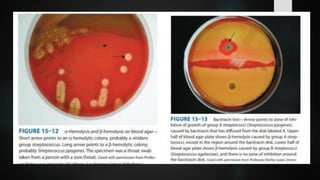
Streptococcus Agalactiae Bacteria Microbiology Lecture

Embed presentation
Download to read offline












Streptococcus agalactiae, or Group B Streptococcus, is associated with several diseases including neonatal meningitis, pneumonia, local skin infections, sepsis, and infective endocarditis. Key characteristics include being gram-positive cocci in chains with a polysaccharide capsule, and laboratory diagnosis involves gram stain, culture, and specific tests like the Camp test. Treatment typically involves penicillin G during childbirth, with preventive measures such as administering ampicillin to mothers with risk factors.